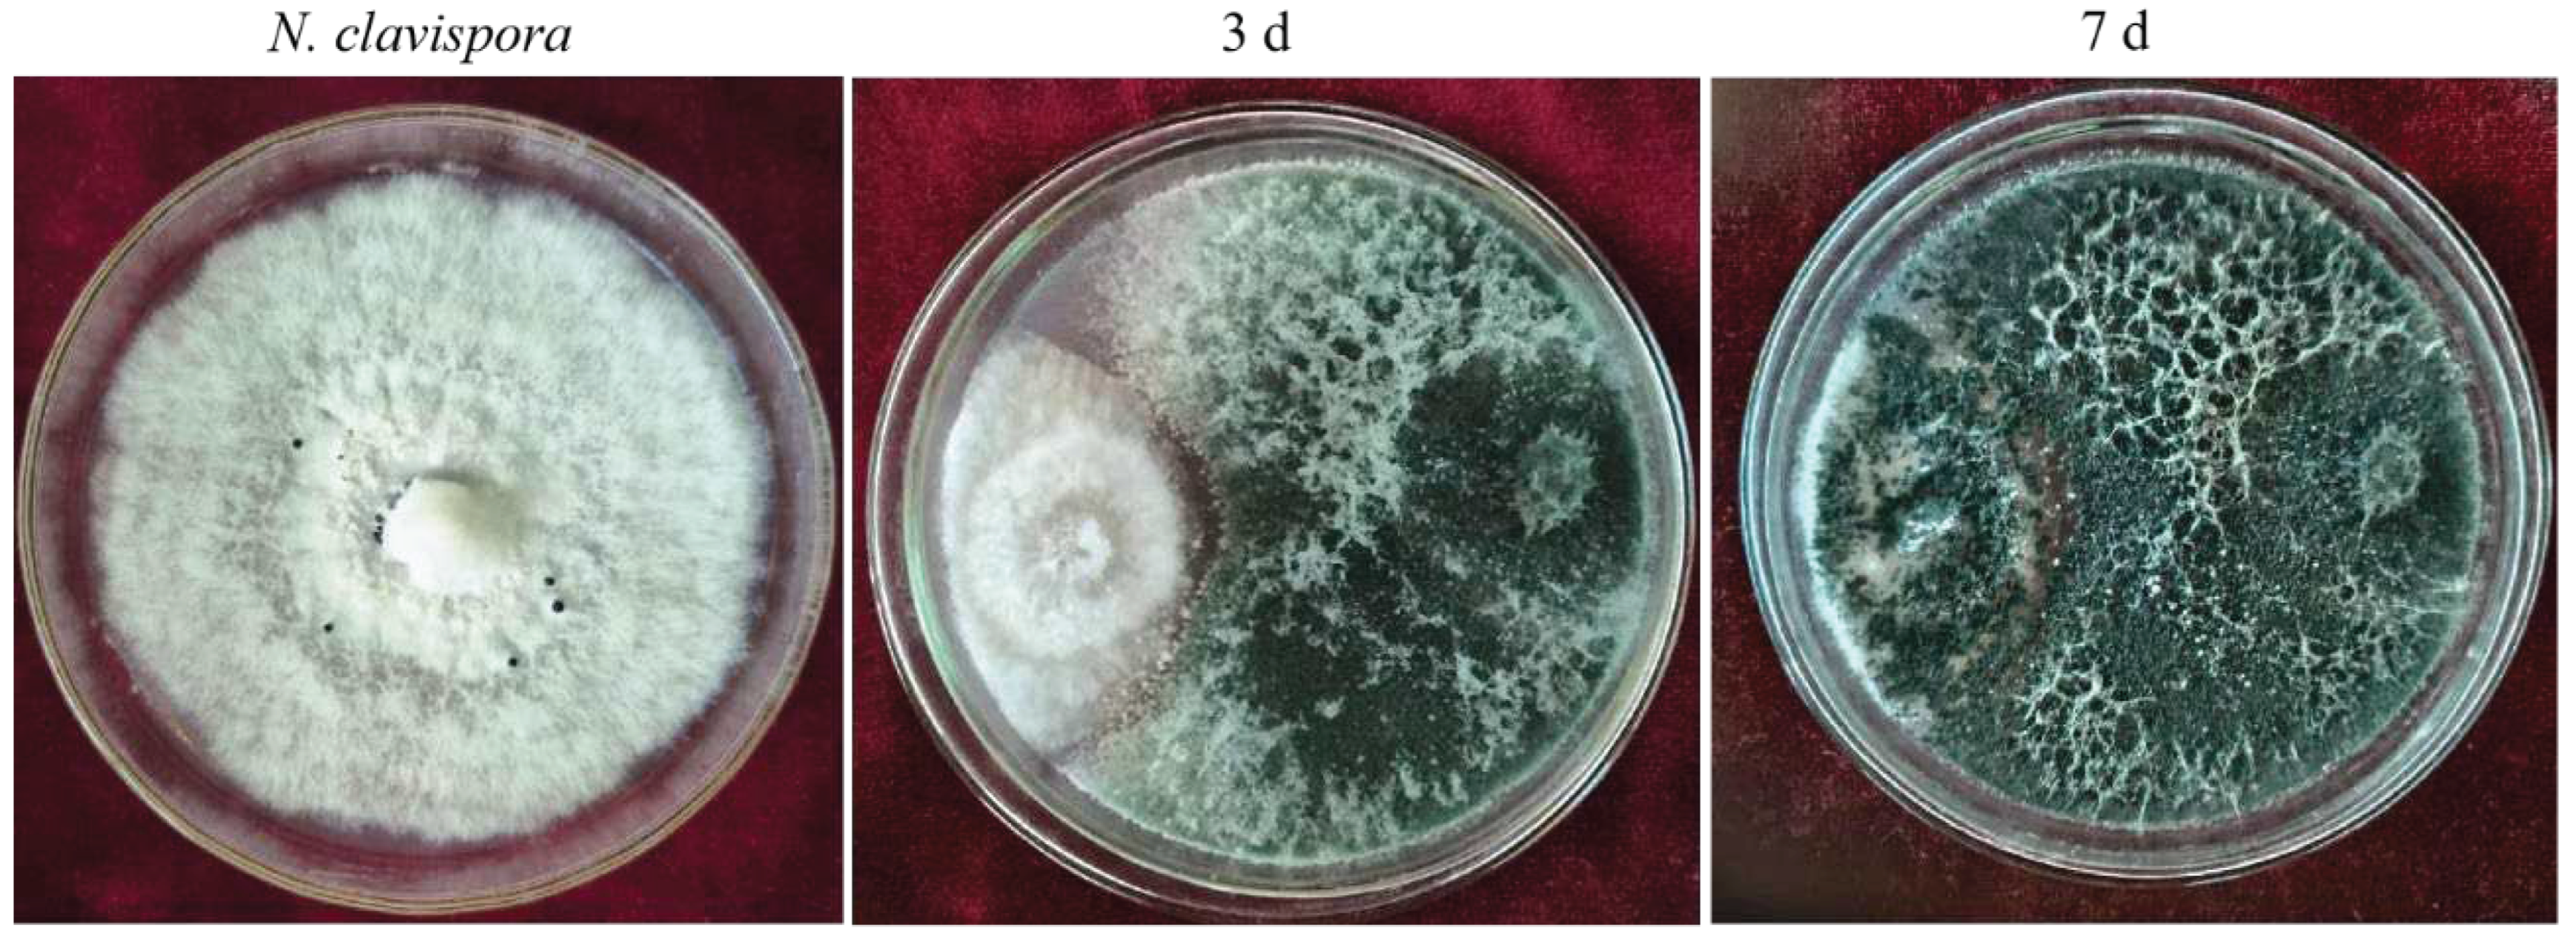
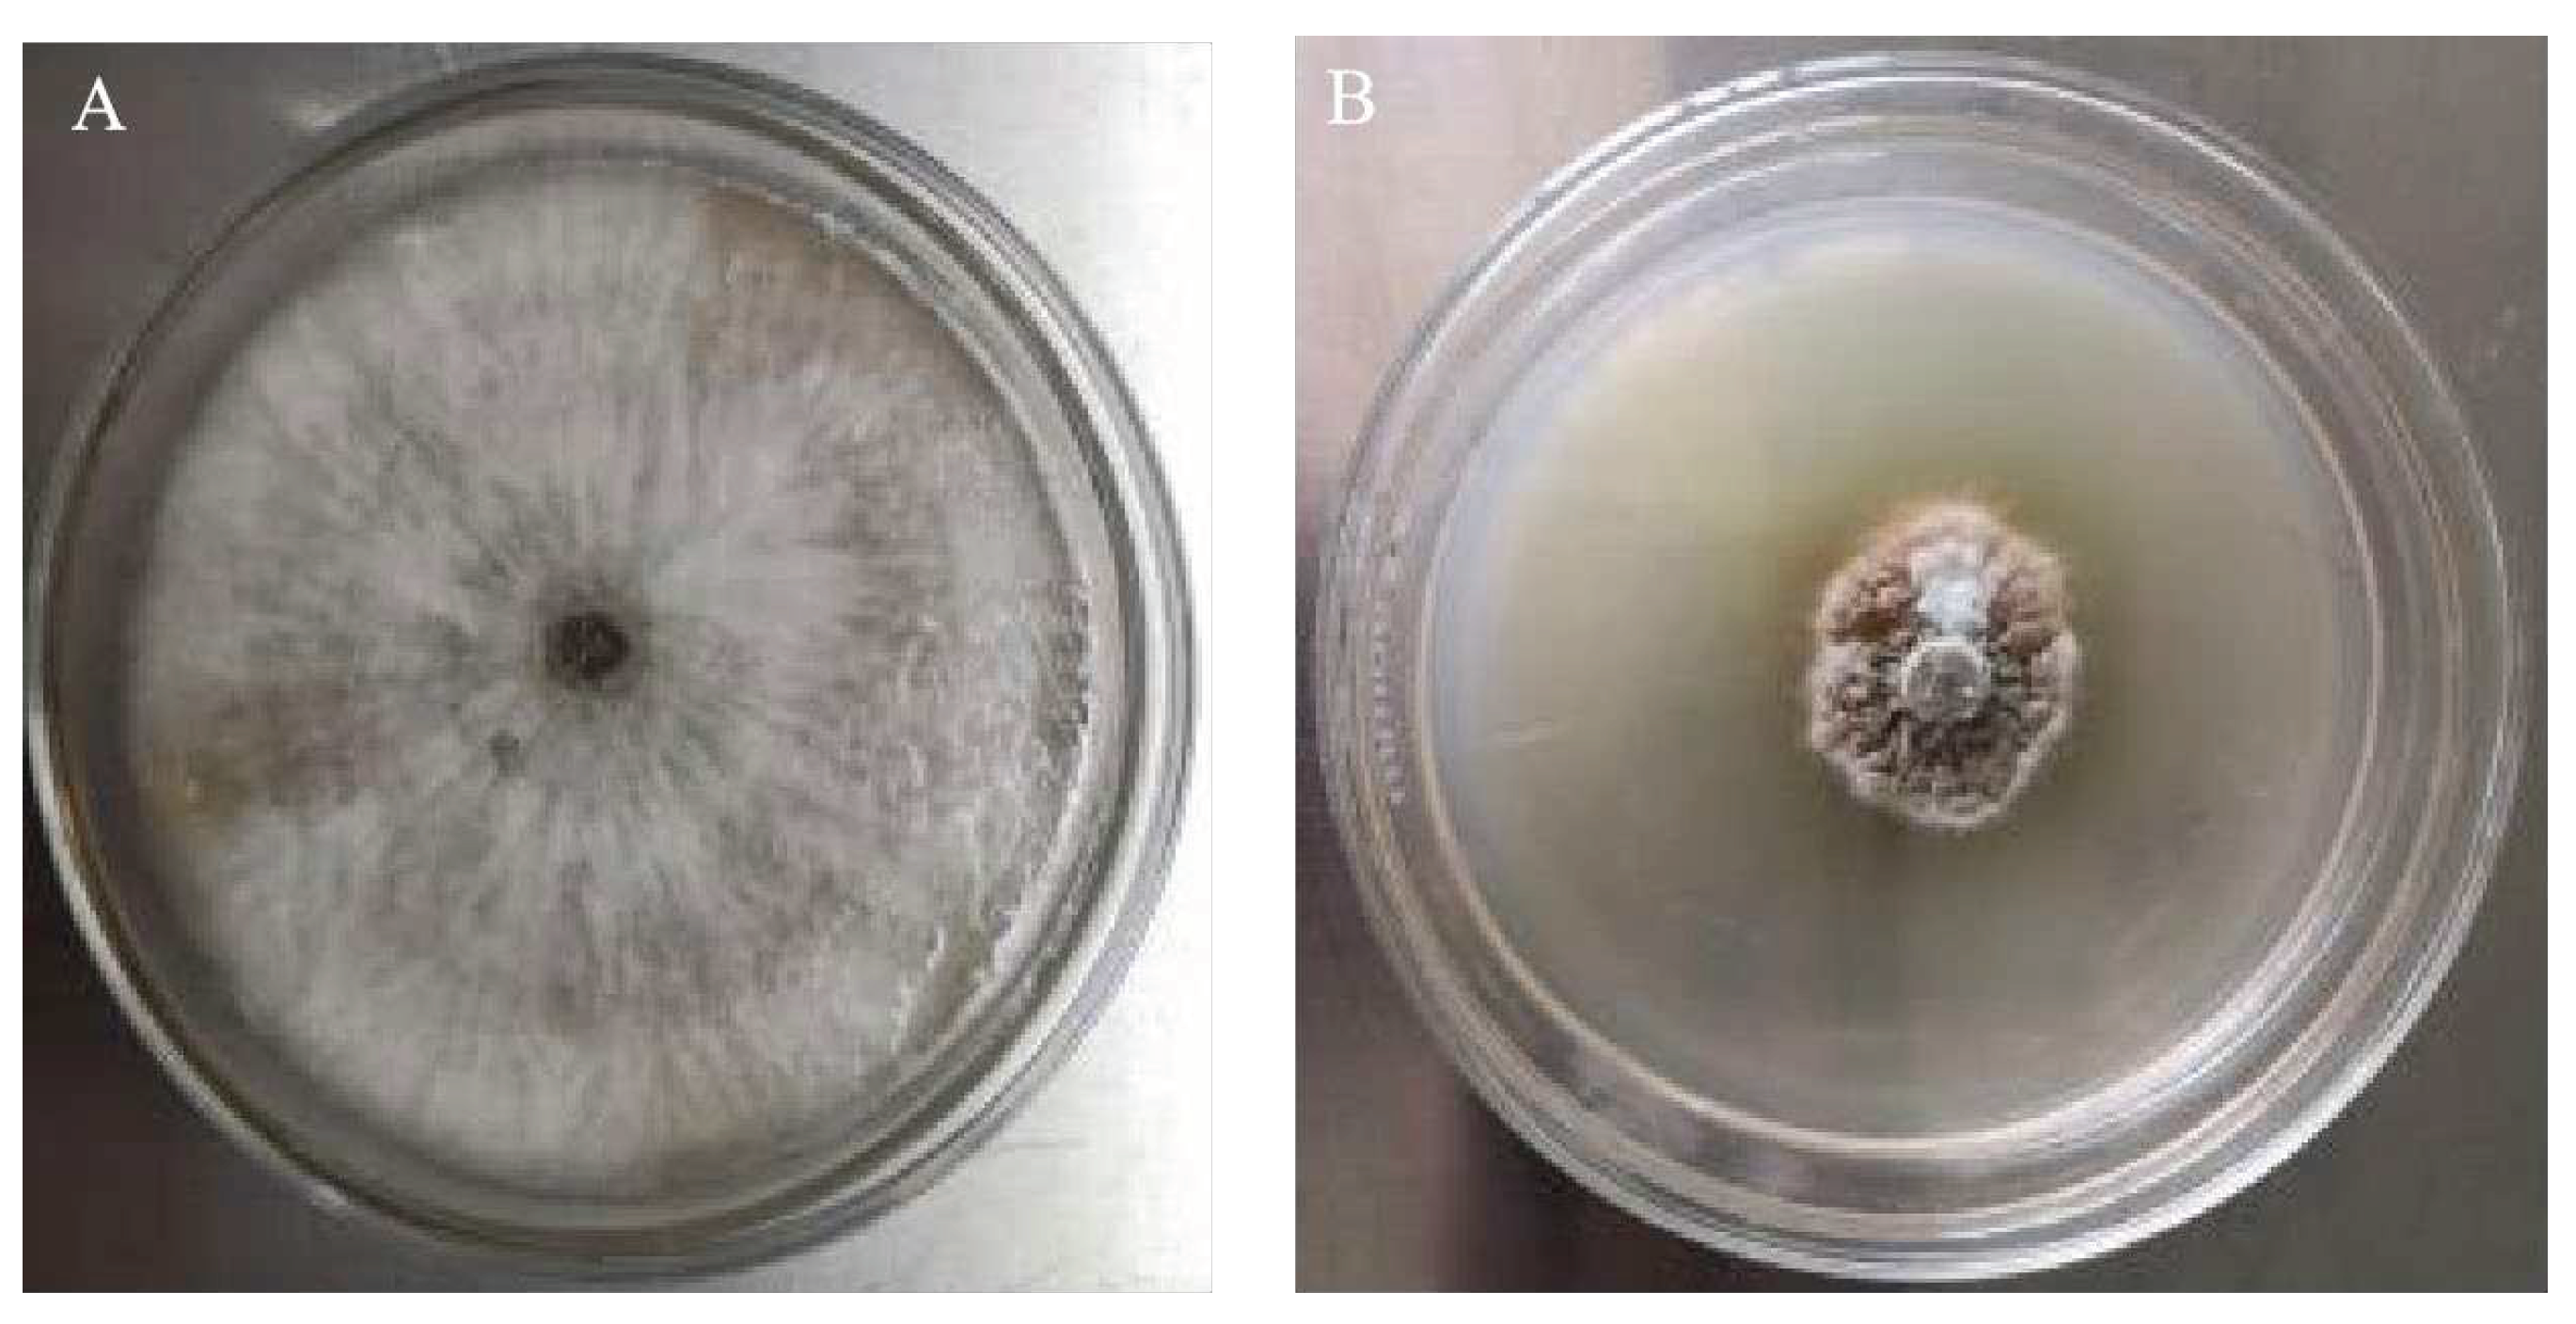

Submitted:
12 February 2024
Posted:
14 February 2024
You are already at the latest version
Abstract
Keywords:
1. Introduction
2. Materials and Methods
2.1. Plant Pathogen and Plant Materials
2.2. Isolation and Screen of Trichoderma strains
2.3. Morphological and Molecular identification of Trichoderma CMT10
2.4. Biocontrol Mechanism of Trichoderma CMT10 against N. clavispora
2.4.1. Inhibitory effects of volatile compounds from Trichoderma CMT10 on N. clavispora
2.4.2. Inhibitory effects of Non-volatile compounds from Trichoderma CMT10 on N. clavispora
2.4.3. Hyperparasitism of Trichoderma CMT10 on N. clavispora
2.5. Growth Promotion Properties of Trichoderma CMT10
2.6. Control Effects of Trichoderma CMT10 on Strawberry Root Rot
2.7. Growth-Promoting Effects of Trichoderma CMT10 on Strawberry Seedlings
2.8. Data Statistics and Analysis
3.1. Screening of Trichoderma Strains with Inhibitory Effects on N. clavispora
| Treatments | Colony diameter | Inhibition rate |
|---|---|---|
| CMT10 | 2.93±0.153 | 65.49 a |
| CMT4 | 4.13±0.058 | 51.37 b |
| CMGF3 | 8.50±0.000 | - |
3.2. Identification of Trichoderma CMT10
3.3. Biocontrol Mechanism of Trichoderma CMT10 against N. clavispora
3.3.1. Inhibition Rates of Volatile Metabolites from Trichoderma CMT10 on N. clavispora
3.3.2. Inhibition Rates of Non-volatile Metabolites from Trichoderma CMT10 on N. clavispora
3.3.3. Hyperparasitism of Trichoderma CMT10 on N. clavispora
2.4. Determination of Growth-Promoting Characteristics of T. asperellum CMT10
2.5. Biocontrol Efficacy of T. asperellum CMT10 against Strawberry Root Rot
| Treatments | Disease index | Control efficiency (%) |
|---|---|---|
| CMGF3 | 84.00±0.04a | - |
| CMT10 | 0.00±0.00c | - |
| CMGF3+CMT10 | 31.00±0.61b | 63.00±0.07a |
| CK | 0.00±0.00c | - |
2.6. Growth-Promoting Effects of T. asperellum CMT10 on Strawberry Seedlings
4. Discussion
4.1. Significance of Exploring Biocontrol Resources for Strawberry Root Rot
4.2. Biocontrol Mechanism of T. asperellum CMT10
4.3. Practical Application of Trichoderma asperellum CMT10
5. Conclusions
Author Contributions
Funding
Data Availability Statement
Conflicts of Interest
References
- Basu, A.; Nguyen, A.; Betts, N.M.; Lyons, T. J. Strawberry as a functional food:An evidence-based review. Crit. Rev. Food Sci. Nutr. 2014, 54, 790–806.
- Ji, Y.; Li, X.; Gao, Q.H.; Geng, C.; Duan, K. Colletotrichum species pathogenic to strawberry: discovery history, global diversity, prevalence in China, and the host range of top two species. Phytopathol Res. 2022, 4, 42. [CrossRef]
- Wang, M.Y.; Du,Y.Q.; Cai,W.W.; Wang, Z.H.; Zhu, J.Q. Effect of complex antagonistic bacteria on controlling strawberry root rot. J. Agric. Sci. Technol. 2020, 22, 100-110.
- Lazcano, C.; Boyd, E.; Holmes, G.; Hewavitharana, S.; Pasulka, A.; Ivors, K. The rhizosphere microbiome plays a role in the resistance to soil-borne pathogens and nutrient uptake of strawberry cultivars under field conditions. Sci. Rep. 2021, 11, 3188. [CrossRef]
- Iqbal, M.; Jamshaid, M.; Zahid, M.A.; Andreasson, E.; Vetukuri, R.A.; Stenberg, J.A. Biological control of strawberry crown rot, root rot and grey mould by the beneficial fungus Aureobasidium pullulans. Bio-Control. 2021, 66, 535-545.
- Baggio, J.S.; Cordova, L.G.; Peres, N.A. Sources of inoculum and survival of 22 Macrophomina phaseolina in Florida strawberry fields. Plant Dis. 2019, 103, 2417-2424. [CrossRef]
- Feliziani, E.; Romanazzi, G. Postharvest decay of strawberry fruit: etiology, epidemiology, and disease management. J. Berry Res. 2016, 6, 47–63. [CrossRef]
- Hong, S.; Kim, T.Y.; Won, S.J.; Moon, J.H.; Ajuna, H.B.; Kim, K. .; Ahn, Y.S. Control of fungal diseases and fruit yield improvement of strawberry using Bacillus velezensis CE100. Microorganisms 2022, 10, 365. [CrossRef]
- Hu, Y.J.; Yang, H.M.; Jin, J.; Yan, H.H.; Wang, J.P.; Zhang, R.Q. Synergistic activity of antagonistic Trichoderma spp. and Rhizoctonia solani increases disease severity on strawberry petioles. Eur. J. Plant Pathol. 2022,164, 375–389. [CrossRef]
- Abdel-lateif, K.S. Trichoderma as biological control weapon against soil borne plant pathogens. Afr. J. Biotechnol. 2017, 16, 2299–2306.
- Benítez, T.; Rincón, A.M.; Limón, M.C.; Codón, A.C. Biocontrol mechanisms of Trichoderma strains. Int. Microbiol. 2004, 7, 249-260.
- Ferreira, F.V.; Musumeci, M.A. Trichoderma as biological control agent: scope and prospects to improve efficacy. World J. Microbiol. Biotechnol. 2021, 37, 90. [CrossRef]
- Zhang, H.; Du, G.D.; Song, Y.N.; Lu, X.F.; Ying, N. Screening, identification and the effect validation of Trichoderma against the root rot of strawberry. Journal of Shenyang Agricultural University 2015, 46, 654-660.
- Mercado, J.A.; Barceló, M.; Pliego, C.; Rey, M.; Caballero, J.L.; Muñoz-Blanco, J.; Ruano-Rosa, D.; López-Herrera, C.; de Los Santos, B.; Romero-Muñoz, F.; Pliego-Alfaro, F. Expression of the β-1,3-glucanase gene bgn13.1 from Trichoderma harzianum in strawberry increases tolerance to crown rot diseases but interferes with plant growth. Transgenic Res. 2015, 24, 979-989. [CrossRef]
- Rees, H.J.; Drakulic, J.; Cromey, M.G.; Bailey, A.M.; Foster, G.D. Endophytic Trichoderma spp. can protect strawberry and privet plants from infection by the fungus Armillaria mellea. PLoS ONE 2022,17, e0271622. [CrossRef]
- Mirzaeipour, Z.; Bazgir, E.; Zafari, D.; Darvishnia, M. Selection and biocontrol efficiency of Trichoderma isolates against Rhizoctonia root rot and their growth promotion effects on strawberry plants. J. Plant Pathol. 2023, 105, 1563–1579. [CrossRef]
- Debbi, A.; Boureghda, H.; Monte, E.; Hermosa, R. Distribution and genetic variability of Fusarium oxysporum associated with tomato diseases in Algeria and a biocontrol strategy with indigenous Trichoderma spp. Front Microbiol. 2018, 9, 282. [CrossRef]
- Pimentel, M.F.; Arnão, E.; Warner, A.J.; Subedi, A.; Rocha, L.F.; Srour, A.; Bond, J.P.; Fakhoury, A.M. Trichoderma isolates inhibit Fusarium virguliforme growth, reduce root rot, and induce defense-related genes on soybean seedlings. Plant Dis. 2020, 104, 1949-1959. [CrossRef]
- Shaigan, S.; Seraji, A.; Moghaddam, S.A. Identification and investigation on antagonistic effect of Trichoderma spp. on tea seedlings white foot and root rot (Sclerotium rolfsii Sacc.) in vitro condition. Pak J. Biol. Sci. 2008, 11,2346-2350.
- Yang H. Classification and identification of Trichoderma. China Land Press:Beijing, China, 2009; pp. 14–20.
- White, T. J.; Bruns, T.; Lee, S.; Taylor, J. Amplification and direct sequencing of fungal ribosomal RNA genes for phylogenetics,” in PCR Protocols: A Guide to Methods and Applications. Academic Press: San Diego, America; 1990; pp. 315–322.
- O’donnell, k.; Kistler, H.C.; Cigelnik, E.; Ploetz, R.Mul-tiple evolutionary origins of the fungus causing Panama disease of banana: concordant evidence from nuclear and mitochondrial gene genealogies. Proc. Natl. Acad. Sci. U.S.A.1998, 95, 2044-2049. [CrossRef]
- Damodaran, T.; Rajan, S.; Muthukumar, M.; Ram, G.; Yadav, K.; Kumar, S.; Ahmad, I.; Nidhi, K.; Mishra, V.K.; Vinay,K.; Jha Sunil, K. Biological management of banana Fusarium wilt caused by Fusarium oxysporum f. sp. cubense tropical race 4 using antagonistic fungal isolate CSR-T-3 (Trichoderma reesei). Front. Microbiol. 2020,11, 595845.
- G, K.A.; L, X.G.; L, Y.G.; Z,T.B.; W, S.L. Potential of Trichoderma harzianum and T. atroviride to Control Botryosphaeria berengeriana f. sp. piricola, the cause of apple ring rot. J. Phytopathology 2002, 150, 271–276.
- Nautiyal, C.S. An efficient microbiological growth medium for screening phosphate solubilizing microorganisms. FEMS Microbiol. Lett. 1999, 170, 265–270. [CrossRef]
- Shin, S.H.; Lim, Y.; Lee, S.E.; Yang, N.W.; Rhee, J.H. CAS agar diffusion assay for the measurement of siderophores in biological fluids. J. Microbiol. Methods 2001, 44, 89–95. [CrossRef]
- Liaqat, F.; Eltem, R. Identification and characterization of endophytic bacteria isolated from in vitro cultures of peach and pear rootstocks. 3 Biotech. 2016, 6,120. [CrossRef]
- 28. Yao; C.X.; Li X.j.; Li Q.; Xing, G.Z.; Fang, W.Y.; Li, C.H.; Zhang, Y.Y.; Yao, C.X.; Xu, M.; Li, F.F.; Song, R.F.; Zhang, W.M.; Li, S.J.; Shen, X.; Zhang, D.F. Screening and identification of antagonistic bacteria against tobacco Fusarium root rot and evaluation of their effects on growth promoting and disease control. Chinese Journal of Biological Control 2021, 37,1066-1072.
- Brick, J.M.; Bostock, R.M.; Silversone, S.E. Rapid in situ assay for indole acetic acid production by bacteria immobilized on nitrocellulose membrane. Appl. Environ. Microbiol. 1991, 57, 535–538. [CrossRef]
- Vestberg, M.; Kukkonen, S.; Saari, K; Parikka, P.; Huttunen, J.; Tainio, L.; Devos, N.; Weekers, F.; Kevers, C.; Thonart, P.; Lemoine, M.C.; Cordier, C.; Alabouvette, C.; Gianinazzi, S. Microbial inoculation for improving the growth and health of micropropagated strawberry. Appl. Soil Ecol. 2004, 27, 243-258.
- Zhang, M.; Kong, Z.; Fu, H.; Shu, X.; Xue, Q.; Lai, H.; Guo, Q. Rhizosphere microbial ecological characteristics of strawberry root rot. Front. Microbiol. 2023, 14, 1286740. [CrossRef]
- Elad, Y.; Chet, I.; Henis, Y. Biological control of Rhizoctonia solani in strawberry fields by Trichoderma harzianum. Plant Soil 1981, 60, 245–254. [CrossRef]
- Hernández-Muñiz, P.; Borrero, C.; Ordóñez-Martín, J.; Pastrana, A.M.; Avilés, M. Optimization of the use of industrial wastes in Anaerobic soil disinfestation for the control of Fusarium wilt in strawberry. Plants (Basel) 2023, 12, 3185. [CrossRef]
- Tyśkiewicz, R.; Nowak, A.; Ozimek, E.; Jaroszuk-Ściseł, J. Trichoderma: the current status of its application in agriculture for the biocontrol of fungal phytopathogens and stimulation of plant growth. Int. J. Mol. Sci. 2022, 23, 2329. [CrossRef]
- Yao, X.; Guo, H.; Zhang, K.; Zhao, M.; Ruan, J.; Chen, J. Trichoderma and its role in biological control of plant fungal and nematode disease. Front Microbiol. 2023, 14,1160551. [CrossRef]
- Mohiddin, F.A.; Padder, S.A.; Bhat, A.H.; Ahanger, M.A.; Shikari, A.B.; Wani, S.H., Bhat, F.A.; Nabi, S.U.; Hamid, A.; Bhat, N.A.; Sofi, N.R.; Waza, S.A.; Hamid, B.; Parveen, S.; Hussain, A.; Bhat, A.N.; Ali, O.M.; Dar, M.S.; Abdel Latef, A.A.H. Phylogeny and optimization of Trichoderma harzianum for Chitinase production: evaluation of their antifungal behaviour against the prominent soil borne phyto-pathogens of temperate India. Microorganisms 2021, 9,1962.
- Risoli, S.; Cotrozzi, L.; Sarrocco, S.; Nuzzaci, M.; Pellegrini, E.; Vitti, A. Trichoderma-induced resistance to Botrytis cinerea in Solanum species: a meta-analysis. Plan. Theory 2022, 11,180. [CrossRef]
- Kottb, M.; Gigolashvili, T.; Großkinsky, D.K.; Piechulla, B. Trichoderma volatiles effecting Arabidopsis: from inhibition to protection against phytopathogenic fungi. Front. Microbiol. 2015, 6, 995. [CrossRef]
- Maruyama, C.R.; Bilesky-José, N.; de Lima, R.; Fraceto, L.F. Encapsulation of Trichoderma harzianum preserves enzymatic activity and enhances the potential for biological control. Front. Bioeng. Biotechnol. 2020, 8, 225. [CrossRef]
- Naglot, A.; Goswami, S.; Rahman, I.; Shrimali, D.D.; Yadav, K.K.; Gupta, V.K.; Veer, V. Antagonistic potential of native Trichoderma viride strain against potent tea fungal pathogens in north east India. Plant Pathol. J. 2015, 31, 278–289. [CrossRef]
- Manganiello, G.; Sacco, A.; Ercolano, M.R.; Vinale, F.; Lanzuise, S.; Pascale, A.; Napolitano, M.; Lombardi, N.; Lorito, M.; Woo, S.L. Modulation of tomato response to Rhizoctonia solani by Trichoderma harzianum and its secondary metabolite harzianic acid. Front. Microbiol. 2018, 9,1966. [CrossRef]
- Shaw, S.; Le Cocq, K.; Paszkiewicz, K.; Moore, K.; Winsbury, R.; de Torres Zabala, M.; Studholme, D.J.; Salmon, D.; Thornton,C.R.; Grant,M.R. Transcriptional reprogramming underpins enhanced plant growth promotion by the biocontrol fungus Trichoderma hamatum GD12 during antagonistic interactions with Sclerotinia sclerotiorum in soil. Mol. Plant Pathol. 2016, 17,1425–1441. [CrossRef]
- Hewedy, O.A.; Abdel Lateif, K.S.; Seleiman, M.F.; Shami, A.; Albarakaty, F.M.; M El-Meihy, R. Phylogenetic diversity of Trichoderma strains and their antagonistic potential against soil-borne pathogens under stress conditions. Biology (Basel) 2020, 9,189. [CrossRef]
- Larran, S.; Santamarina Siurana, M.P.; Roselló Caselles, J.; Simón, M.R.; Perelló, A. In vitro antagonistic activity of Trichoderma harzianum against Fusarium sudanense causing seedling blight and seed rot on wheat. ACS Omega 2020, 5, 23276-23283. [CrossRef]
- Sood, M.; Kapoor, D.; Kumar, V.; Sheteiwy, M.S.; Ramakrishnan, M.; Landi, M.; Araniti, F.; Sharma, A. Trichoderma: The secrets of a multitalented biocontrol agent. Plants 2020, 9, 762. [CrossRef]
- Jogaiah, S.; Abdelrahman, M.; Tran, L.P.; Ito, S.I. (). Different mechanisms of Trichoderma virens-mediated resistance in tomato against Fusarium wilt involve the jasmonic and salicylic acid pathways. Mol. Plant Pathol. 2018, 19, 870–882.

| Genea | Primer | Primer sequence (5′-3′) | PCR conditions | Reference |
|---|---|---|---|---|
| ITS | ITS1 ITS4 |
TCCGTAGGTGAACCTGCGG | 94°C for 5 min (94°C for 30 s, 55°C for30 s, and 72°C for 40 s) × 35 cycles, 72°C for 7 min |
[21] |
| TCCTCCGCTTATTGATATGC | ||||
| tef-1α | TEF-F | TGGGCCATCAACTGAGAAAGA | 94°C for 5 min (94°C for 30 s, 53°C for 30 s, and 72°C for 1 min) × 35 cycles, 72°C for 7 min |
[22] |
| TEF-R | TCTCCCTACACTTCAACTGCACA |
| Code | Culture accession number(s) |
Original name | Accession no. ITS |
Accession no. tef-1α |
|---|---|---|---|---|
| 1 | CEN1463 |
T. asperellum |
MK714888 | MK696646 |
| 2 | T34 |
T. asperellum |
LC123614 | EU077228 |
| 3 | ZJSX5002 |
T. asperellum |
JQ040324 | JQ040480 |
| 4 | KUFA0403 |
T. asperellum |
OM169354 | OP132635 |
| 5 | RM-28 | T. asperellum | MK092975 | MK095221 |
| 6 | TR5 | T. longibrachiatum | KC859426 | KC572116 |
| 7 | Tr5 | T. harzianum | OP938774 | OP948262 |
| 8 | DUCC001 | T. citrinoviride | JF700484 | JF700485 |
| 9 | S206 | T. caerulescens | JN715590 | JN715624 |
| 10 | TW20050 | T. gamsii | KU523894 | KU523895 |
| 11 | YMF1.02659 | T. kunmingense | KJ742800 | KJ742802 |
| 12 | CBS 121219 | T. yunnanense | GU198302 | GU198243 |
| Treatments | Plant height (cm) |
Root length (cm) |
Total fresh weight (g) |
Root fresh weight (g) |
Stem fresh weight (g) |
Root dry weight (g) |
|---|---|---|---|---|---|---|
| CMT10 | 12.57±1.35a | 23.75±2.18a | 13.55±3.53a | 7.18±3.37a | 6.37±2.08a | 2.66±1.00a |
| CK | 10.53±1.41b | 19.67±2.70b | 7.61±1.66b | 3.87±1.59b | 3.74±0.61b | 1.56±0.50b |
Disclaimer/Publisher’s Note: The statements, opinions and data contained in all publications are solely those of the individual author(s) and contributor(s) and not of MDPI and/or the editor(s). MDPI and/or the editor(s) disclaim responsibility for any injury to people or property resulting from any ideas, methods, instructions or products referred to in the content. |
© 2024 by the authors. Licensee MDPI, Basel, Switzerland. This article is an open access article distributed under the terms and conditions of the Creative Commons Attribution (CC BY) license (http://creativecommons.org/licenses/by/4.0/).